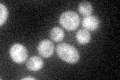
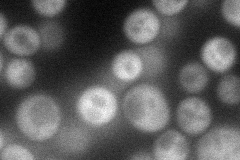
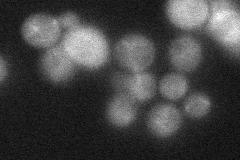

View description
Ser/thr protein kinase; nuclear translocation required for haploid filamentous growth; regulates filamentous growth induced nuclear translocation of Bcy1p, Fus3p, and Sks1p; overproduction causes allele-specific suppression of prp20-10
Localization:
Intensity:
Fold change:
Significance:
-
C’ GFP library in SD
cytosol36.66 -
N' NOP1pr-GFP in SD
cytosol59.2746 -
N' TEF2pr-mCherry in SD

cytosol25.0005 -
N' NATIVEpr-GFP in SD
cytosol28.51 -
N' TEF2pr-VC and Cyto-VN in SD

cytosol38.9416 -
C’ GFP library in SD+DTT

cytosol49.661.35Yes -
C’ GFP library in SD+H2O2

cytosol40.251.09No -
C’ GFP library in Starvation Media

cytosol37.621.02No -
C’ GFP library on the background of Pup2-DaMP

cytosol -
C’ GFP library on the background of CCT mutant

cytosol48.96161.33526No
